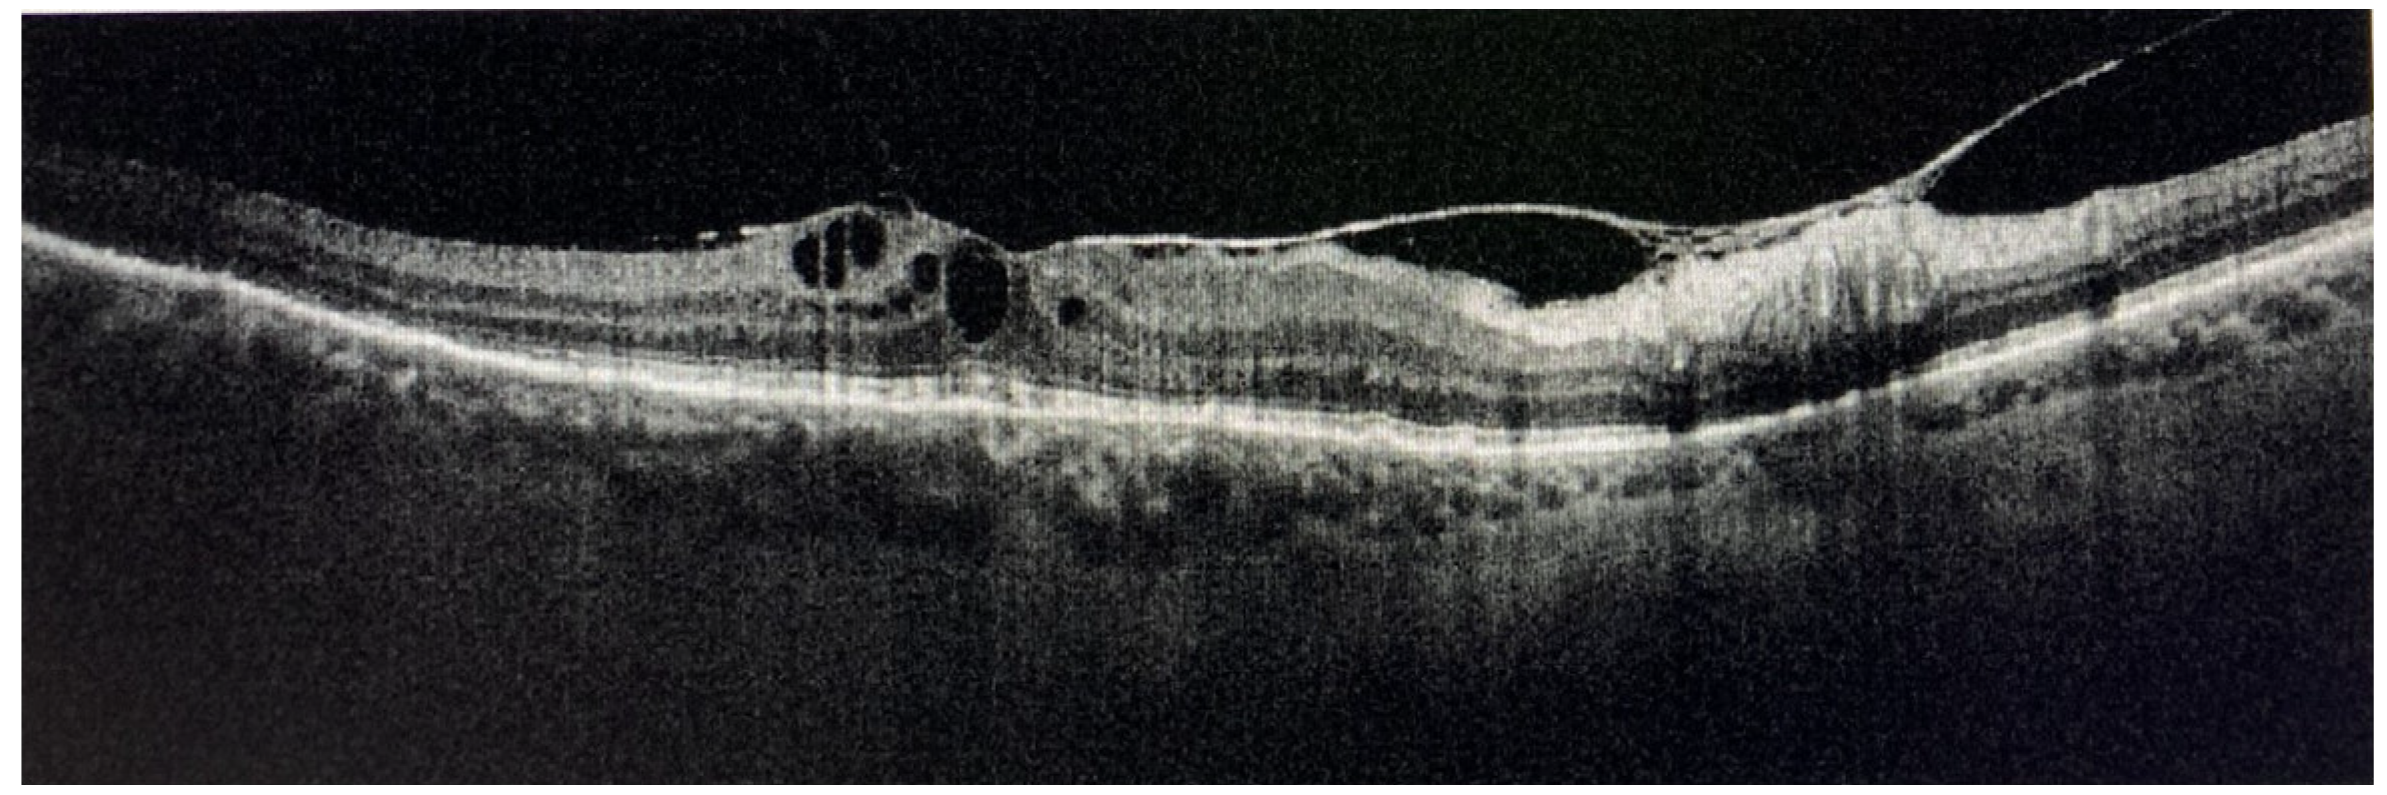
Medicina 58 00898 g019 Medicina 58 00898 g019

Sarcoid Uveitis: An Intriguing Challenger
Abstract
1. Introduction
2. Literature Review
2.1. Epidemiology
2.2. Etiopathogenesis
2.3. Histopathology
2.4. Systemic Sarcoidosis
2.5. Ocular Manifestations
2.6. Ocular Complications
2.7. Differential Diagnosis
2.8. Prognosis
2.9. Systemic Diagnostic Procedures
2.10. Ocular Diagnostic Procedures
- (1)
- diffuse or segmental vascular leakage (peri-phlebitis) caused by retinal vasculitis, with vascular sheathing, situated mainly at the middle and extreme periphery;
- (2)
- macroaneurysms (frequently present in elderly females);
- (3)
- areas of vascular non-perfusion or occlusion predominantly involving veins, sometimes mimicking neo-vascularization;
- (4)
- papillitis (usually bilateral and asymmetrical);
- (5)
2.11. Medical Treatment
2.12. Surgical and Parasurgical Treatment
3. Personal Experience
4. Discussion
4.1. Systemic Involvement
4.2. Ocular Involvement
4.3. Local and Systemic Therapy
5. Conclusions
Author Contributions
Funding
Institutional Review Board Statement
Informed Consent Statement
Data Availability Statement
Acknowledgments
Conflicts of Interest
Methods of Literature Searching
References
- Pasadhika, S.; Rosenbaum, J.T. Ocular sarcoidosis. Clin. Chest. Med. 2015, 36, 669–683. [Google Scholar] [CrossRef] [PubMed]
- Jabs, D.A.; Nussenblatt, R.B.; Rosenbaum, J.T.; Standardization of Uveitis Nomenclature (SUN) Working Group. Standardization of uveitis nomenclature for reporting clinical data. Results of the First International Workshop. Am. J. Ophthalmol. 2005, 140, 509–516. [Google Scholar] [PubMed]
- Rothova, A. Ocular involvement in sarcoidosis. Br. J. Ophthalmol. 2000, 84, 110–116. [Google Scholar] [CrossRef]
- Groen, F.; Rothova, A. Ocular involvement in sarcoidosis. Semin. Respir. Crit. Care Med. 2017, 38, 514–522. [Google Scholar]
- Ma, S.P.; Rogers, S.L.; Hall, A.J.; Hodgson, L.; Brennan, J.; Stawell, R.J.; Lim, L.L. Sarcoidosis-related uveitis: Clinical presentation, disease course, and rates of systemic disease progression after uveitis diagnosis. Am. J. Ophthalmol. 2019, 198, 30–36. [Google Scholar] [CrossRef]
- Herbort, C.P.; Rao, N.A.; Mochizuki, M.; Members of Scientific Committee of First International Workshop on Ocular Sarcoidosis. International criteria for the diagnosis of ocular sarcoidosis: Results of the first International Workshop on Ocular Sarcoidosis (IWOS). Ocul. Immunol. Inflamm. 2009, 17, 160–169. [Google Scholar] [CrossRef]
- Mochizuki, M.; Smith, J.R.; Takase, H.; Kaburaki, T.; Acharya, N.R.; Rao, N.A.; International Workshop on Ocular Sarcoidosis Study Group. Revised criteria of International Workshop on Ocular Sarcoidosis (IWOS) for the diagnosis of ocular sarcoidosis. Br. J. Ophthalmol. 2019, 103, 1418–1422. [Google Scholar] [CrossRef]
- Jouveshomme, S.; Fardeau, C.; Finet, J.F.; Akakpo, J.P.; Beigelman, C.; Hoang, P.L.; Derenne, J.P. Alveolar lymphocytosis in patients with chronic uveitis: Relationship to sarcoidosis. Lung 2001, 179, 305–317. [Google Scholar] [CrossRef]
- The Standardization of Uveitis Nomenclature (SUN) Working Group. Classification Criteria for Sarcoidosis-Associated Uveitis. Am. J. Ophthalmol. 2021, 228, 220–230. [Google Scholar] [CrossRef]
- Niederer, R.L.; Al-Janabi, A.; Lightman, S.L.; Tomkins-Netzer, O. Serum Angiotensin-Converting Enzyme Has a High Negative Predictive Value in the Investigation for Systemic Sarcoidosis. Am. J. Ophthalmol. 2018, 194, 82–87. [Google Scholar] [CrossRef] [PubMed]
- Sève, P.; Jamilloux, Y.; Tilikete, C.; Gerfaud-Valentin, M.; Kodjian, L.; El Jammal, T. Ocular sarcoidosis. Semin. Respir. Crit. Care Med. 2020, 41, 673–688. [Google Scholar] [CrossRef]
- Sahin, O.; Ziaei, A.; Karaismailoğlu, E.; Taheri, N. The serum angiotensin converting enzyme and lysozyme levels in patients with ocular involvement of autoimmune and infectious diseases. BMC Ophthalmol. 2016, 16, 19. [Google Scholar] [CrossRef]
- Bonfioli, A.A.; Orefice, F. Sarcoidosis. Semin. Ophthalmol. 2005, 20, 177–182. [Google Scholar] [CrossRef]
- Baughman, R.P.; Teirstein, A.S.; Judson, M.A.; Rossman, M.D.; Yeager, H., Jr.; Bresnitz, E.A.; DePalo, L.; Hunninghake, G.; Iannuzzi, M.C.; Johns, C.J.; et al. Case Control Etiologic Study of Sarcoidosis (ACCESS) research group. Clinical characteristics of patients in a case control study of sarcoidosis. Am. J. Respir. Crit. Care Med. 2001, 164, 1885–1889. [Google Scholar] [CrossRef] [PubMed]
- Cameli, P.; Caffarelli, C.; Refini, R.M.; Bergantini, L.; D’Alessandro, M.; Armati, M.; Tomai Pitinca, M.D.; Sestini, P.; Gonnelli, S.; Bargagli, E. Hypercalciuria in Sarcoidosis: A Specific Biomarker with Clinical Utility. Front. Med. 2020, 7, 568020. [Google Scholar] [CrossRef]
- Varol, A.; Seifert, O.; Anderson, C.D. The skin pathergy test: Innately useful? Arch. Dermatol. Res. 2010, 302, 155–168. [Google Scholar] [CrossRef] [PubMed]
- Kutlubay, Z.; Tüzün, Y.; Wolf, R. The Pathergy Test as a Diagnostic Tool. Skinmed 2017, 15, 97–104. [Google Scholar] [PubMed]
- Zhou, E.R.; Arce, S. Key Players and Biomarkers of the Adaptive Immune System in the Pathogenesis of Sarcoidosis. Int. J. Mol. Sci. 2020, 21, 7398. [Google Scholar] [CrossRef]
- Crouser, E.D.; Maier, L.A.; Wilson, K.C.; Bonham, C.A.; Morgenthau, A.S.; Patterson, K.C.; Abston, E.; Bernstein, R.C.; Blankstein, R.; Chen, E.S. Diagnosis and Detection of Sarcoidosis. An Official American Thoracic Society Clinical Practice Guideline. Am. J. Respir. Crit. Care Med. 2020, 201, e26–e51. [Google Scholar] [CrossRef] [PubMed]
- Valeyre, D.; Prasse, A.; Nunes, H.; Uzunhan, Y.; Brillet, P.-Y.; Müller-Quernheim, J. Sarcoidosis. Lancet 2014, 383, 1155–1167. [Google Scholar] [CrossRef]
- Baarsma, G.S.; la Hey, E.; Glasius, E.; de Vries, J.; Kijlstra, A. The predictive value of serum angiotensin converting enzyme and lysozyme levels in the diagnosis of ocular sarcoidosis. Am. J. Ophthalmol. 1987, 104, 211–217. [Google Scholar] [CrossRef]
- Stavrou, P.; Linton, S.; Young, D.W.; Murray, P.I. Clinical diagnosis of ocular sarcoidosis. Eye 1997, 11, 365–370. [Google Scholar] [CrossRef] [PubMed]
- Birnbaum, A.D.; Oh, F.S.; Chakrabarti, A.; Tessler, H.H.; Goldstein, D.A. Clinical features and diagnostic evaluation of biopsy-proven ocular sarcoidosis. Arch. Ophthalmol. 2011, 129, 409–413. [Google Scholar] [CrossRef] [PubMed]
- Pivetti-Pezzi, P.; Accorinti, M.; la Cava, M. Endogenous uveitis: An analysis of 1417 cases. Ophthalmologica 1996, 10, 234–238. [Google Scholar] [CrossRef] [PubMed]
- Mercanti, A.; Parolini, B.; Bonora, A. Epidemiology of endogenous uveitis in northeastern Italy. Analysis of 655 new cases. Acta Ophthalmol. Scand. 2001, 79, 64–68. [Google Scholar] [CrossRef]
- Barisani-Asenbauer, T.; Maca, S.M.; Mejdoubi, L. Uveitis—A rare disease often associated with systemic diseases and infections: A systemic review of 2619 patients. Orphanet. J. Rare Dis. 2012, 7, 57–64. [Google Scholar] [CrossRef]
- Jones, N.P. The Manchester uveitis clinic: The first 3000 patients—Epidemiology and casemix. Ocul. Immunol. Inflamm. 2001, 23, 118–126. [Google Scholar] [CrossRef]
- Llorenç, V.; Mesquida, M.; Sainz de la Maza, M. Epidemiology of uveitis in a Western urban multiethnic population. The challenge of globalization. Acta Ophthalmol. 2015, 93, 561–567. [Google Scholar] [CrossRef]
- Grajewski, R.S.; Caramoy, A.; Frank, K.F. Spectrum of uveitis in a German tertiary center: Review of 474 consecutive patients. Ocul. Immunol. Inflamm. 2015, 23, 346–352. [Google Scholar] [CrossRef]
- Jakob, E.; Reuland, M.S.; Mackensen, F. Uveitis subtypes in a German interdisciplinary uveitis center—Analysis of 1916 patients. J. Rheumatol. 2009, 36, 127–136. [Google Scholar] [CrossRef]
- Tran, V.T.; Auer, C.; Guex-Crosier, Y. Epidemiology of uveitis in Switzerland. Ocul. Immunol. Inflamm. 1994, 2, 169–176. [Google Scholar] [CrossRef] [PubMed]
- Liberman, P.; Gauro, F.; Berger, O.; Urzua, C.A. Causes of uveitis in a tertiary center in Chile: A cross-sectional retrospective review. Ocul. Immunol. Inflamm. 2015, 23, 339–345. [Google Scholar] [CrossRef] [PubMed]
- Bodaghi, B.; Wechsler, B.; Du-Boutin, L.T. Chronic severe uveitis: Classification, search for etiology and therapeutic approach. Rev. Med. Interne. 2003, 24, 794–802. [Google Scholar] [CrossRef]
- Al Dhahri, H.; Al Rubaie, K.; Hemachandran, S. Patterns of uveitis in a university-based tertiary referral center in Riyadh, Saudi Arabia. Ocul. Immunol. Inflamm. 2014, 24, 311–319. [Google Scholar] [CrossRef]
- Nakahara, H.; Kaburaki, T.; Takamoto, M. Statistical analyses of endogenous uveitis patients (2007–2009) in central Tokyo area and comparison with previous studies (1963–2006). Ocul. Immunol. Inflamm. 2015, 23, 291–296. [Google Scholar] [CrossRef]
- Khairallah, M.; Yahia, S.B.; Ladjimi, A. Pattern of uveitis in a referral centre in Tunisia, North Africa. Eye 2007, 21, 33–39. [Google Scholar] [CrossRef]
- Kazokoglu, H.; Onal, S.; Tugal-Tutkun, I. Demographic and clinical features of uveitis in tertiary centers in Turkey. Ophthalmic Epidemiol. 2007, 15, 285–293. [Google Scholar] [CrossRef]
- Rodriguez, A.; Calonge, M.; Pedroza-Seres, M. Referral patterns of uveitis in a tertiary eye care center. Arch. Ophthalmol. 1996, 114, 593–599. [Google Scholar] [CrossRef]
- Cimino, L.; Aldigeri, R.; Salvarani, C. The causes of uveitis in a referral centre of Northern Italy. Int. Ophthalmol. 2010, 30, 521–529. [Google Scholar] [CrossRef]
- Cimino, L.; Aldigeri, R.; Marchi, S.; Mastrofilippo, V.; Viscogliosi, F.; Coassin, M.; Soldani, A.; Savoldi, L.; de Fanti, A.; Belloni, L.; et al. Changes in patterns of uveitis at a tertiary referral center in Northern Italy: Analysis of 990 consecutive cases. Int. Ophthalmol. 2018, 38, 133–142. [Google Scholar] [CrossRef]
- Shirahama, S.; Kaburaki, T.; Nakahara, H. Epidemiology of uveitis (2013–2015) and changes in the patterns of uveitis (2004–2015) in the central Tokyo area: A retrospective study. BMC Ophthalmol. 2018, 18, 189. [Google Scholar] [CrossRef] [PubMed]
- Sartwell, P.E.; Edwards, L.B. Epidemiology of sarcoidosis in the US Navy. Am. J. Epidemiol. 1974, 99, 250–257. [Google Scholar] [CrossRef] [PubMed]
- Westney, G.E.; Judson, M.A. Racial and ethnic disparities in sarcoidosis: From genetics to socioeconomics. Clin. Chest Med. 2006, 27, 453–462. [Google Scholar] [CrossRef] [PubMed]
- Rasmussen, E.R. Geographic variation in sarcoidosis in South Carolina: Its relation to socioeconomic status and health care indicators. Am. J. Epidemiol. 2000, 151, 938. [Google Scholar] [CrossRef] [PubMed][Green Version]
- Arkema, E.V.; Grunewald, J.; Kullberg, S.; Eklund, A.; Askling, J. Sarcoidosis incidence and prevalence: A nationwide register-based assessment in Sweden. Eur. Respir. J. 2016, 48, 1690–1699. [Google Scholar] [CrossRef]
- Hena, K.M. Sarcoidosis Epidemiology: Race Matters. Front. Immunol. 2020, 11, 537382. [Google Scholar] [CrossRef]
- Mirsaeidi, M.; Machado, R.F.; Schraufnagel, D.; Sweiss, N.J.; Baughman, R.P. Racial difference in sarcoidosis mortality in the United States. Chest 2015, 147, 438–449. [Google Scholar] [CrossRef]
- Morimoto, T.; Azuma, A.; Abe, S.; Usuki, J.; Kudoh, S.; Sugisaki, K.; Oritsu, M.; Nukiwa, T. Epidemiology of sarcoidosis in Japan. Eur. Resp. J. 2008, 31, 372–379. [Google Scholar] [CrossRef]
- Reid, G.; Williams, M.; Compton, M.; Silvestri, G.; McAvoy, C. Ocular sarcoidosis prevalence and clinical features in the Northern Ireland population. Eye 2021. [Google Scholar] [CrossRef]
- Soto-Gomez, N.; Peters, J.I.; Nambiar, A.M. Diagnosis and Management of Sarcoidosis. Am. Fam. Physician. 2016, 93, 840–848. [Google Scholar]
- Baughman, R.P.; Culver, D.A. Sarcoidosis. Clin. Chest Med. 2015, 36, 769–776. [Google Scholar] [CrossRef]
- Rybicki, B.A.; Amend, K.L.; Maliarik, M.J.; Iannuzzi, M.C. Photocopier exposure and risk of sarcoidosis in African-American sibs. Sarcoidosis Vasc. Diffus. Lung Dis. 2004, 21, 49–55. [Google Scholar]
- Iannuzzi, M.C.; Fontana, J.R. Sarcoidosis: Clinical presentation, immunopathogenesis, and therapeutics. JAMA 2011, 305, 391–399. [Google Scholar] [CrossRef]
- Rybicki, B.A.; Iannuzzi, M.C.; Frederick, M.M.; Thompson, B.W.; Rossman, M.D.; Bresnitz, E.A.; Terrin, M.L.; Moller, D.R.; Barnard, J.; ACCESS Research Group; et al. Familial aggregation of sarcoidosis. A case-control etiologic study of sarcoidosis (ACCESS). Am. J. Respir. Crit. Care Med. 2001, 164, 2085–2091. [Google Scholar] [CrossRef]
- Heiligenhaus, A.; Wefelmeyer, D.; Wefelmeyer, E.; Rösel, M.; Schrenk, M. The eye as a common site for the early clinical manifestation of sarcoidosis. Ophthalmic Res. 2011, 46, 9–12. [Google Scholar] [CrossRef] [PubMed]
- Judson, M.A. Environmental Risk Factors for Sarcoidosis. Front. Immunol. 2020, 11, 1340. [Google Scholar] [CrossRef] [PubMed]
- Dammacco, R.; Biswas, J.; Kivelä, T.T.; Zito, F.A.; Leone, P.; Mavilio, A.; Sisto, D.; Alessio, G.; Dammacco, F. Ocular sarcoidosis: Clinical experience and recent pathogenetic and therapeutic advancements. Int. Ophthalmol. 2020, 40, 3453–3467. [Google Scholar] [CrossRef]
- Ungprasert, P.; Tooley, A.A.; Crowson, C.S.; Matteson, E.L.; Smith, W.M. Clinical Characteristics of Ocular Sarcoidosis: A Population-Based Study 1976–2013. Ocul. Immunol. Inflamm. 2017, 27, 389–395. [Google Scholar] [CrossRef]
- Yanardag, H.; Tetikkurt, C.; Bilir, M.; Pazarli, H. Clinical features and the prognostic significance of ocular sarcoidosis. Arch. Pulmonol. Resp. Care 2018, 4, 6–11. [Google Scholar]
- Choi, S.Y.; Lee, J.H.; Won, J.-Y.; Shin, J.A.; Park, Y.-H. Ocular Manifestations of Biopsy-Proven Pulmonary Sarcoidosis in Korea. J. Ophthalmol. 2018, 2018, 9308414. [Google Scholar] [CrossRef]
- Baughman, R.P.; Lower, E.E.; du Bois, R.M. Sarcoidosis. Lancet 2003, 361, 111. [Google Scholar] [CrossRef]
- Rossi, G.; Cavazza, A.; Colby, T.V. Pathology of Sarcoidosis. Clin. Rev. Allerg. Immunol. 2015, 49, 36–44. [Google Scholar] [CrossRef] [PubMed]
- Ma, Y.; Gal, A.; Koss, M.N. The pathology of pulmonary sarcoidosis: Update. Sem. Diagn. Pathol. 2007, 24, 150–161. [Google Scholar] [CrossRef]
- Saktivel, P.; Bruder, D. Mechanism of granuloma formation in sarcoidosis. Curr. Opin. Hematol. 2017, 24, 59–65. [Google Scholar] [CrossRef] [PubMed]
- Broos, C.E.; Hendricks, R.W.; Kool, M. T-cell immunology in sarcoidosis: Disruption of a delicate balance between helper and regulatory T-cells. Curr. Opin. Pulm. Med. 2016, 22, 476–483. [Google Scholar] [CrossRef] [PubMed]
- Ramstein, J.; Broos, C.E.; Simpson, L.J.; Ansel, K.M.; Sun, S.S.; Ho, M.E.; Woodruff, P.G.; Bhakta, N.R.; Christian, L.; Nguyen, C.P.; et al. IFN-γ-Producing T-Helper 17.1 Cells Are Increased in Sarcoidosis and Are More Prevalent than T-Helper Type 1 Cells. Am. J. Resp. Crit. Care Med. 2016, 193, 1281–1291. [Google Scholar] [CrossRef] [PubMed]
- Agostini, C.; Adami, F.; Semenzato, G. New pathogenetic insights into the sarcoid granuloma. Curr. Opin. Rheumatol. 2000, 12, 71–76. [Google Scholar] [CrossRef] [PubMed]
- Semenzato, G.; Pezzutto, A.; Chilosi, M.; Pizzolo, G. Redistribution of T lymphocytes in the lymph nodes of patients with sarcoidosis. N. Engl. J. Med. 1982, 306, 48–49. [Google Scholar]
- Iannuzzi, M.C. Advances in the genetics of sarcoidosis. Proc. Am. Thorac. Soc. 2007, 4, 457–460. [Google Scholar] [CrossRef]
- Rybicki, B.A.; Iannuzzi, M.C. Epidemiology of sarcoidosis: Recent advances and future prospects. Semin. Respir. Crit. Care Med. 2007, 28, 22–35. [Google Scholar] [CrossRef]
- Grunewald, J. Genetics of sarcoidosis. Curr. Opin. Pulm. Med. 2008, 14, 434–439. [Google Scholar] [CrossRef] [PubMed]
- Calender, A.; Weichhart, T.; Valeyre, D.; Pacheco, Y. Current Insights in Genetics of Sarcoidosis: Functional and Clinical Impacts. J. Clin. Med. 2020, 9, 2633. [Google Scholar] [CrossRef] [PubMed]
- Moller, D.R.; Rybicki, B.A.; Hamzeh, N.Y.; Montgomery, C.G.; Chen, E.S.; Drake, W.; Fontenot, A.P. Genetic, Immunologic, and Environmental Basis of Sarcoidosis. Ann. Am. Thorac. Soc. 2017, 14, 429–436. [Google Scholar] [CrossRef] [PubMed]
- Chaperon, M.; Pacheco, Y.; Maucort-Boulch, D.; Iwaz, J.; Perard, L.; Broussolle, C.; Jamilloux, Y.; Burillon, C.; Kodjikian, L.; Calender, A. BTNL2 gene polymorphism and sarcoid uveitis. Br. J. Ophthalmol. 2019, 103, 1690–1694. [Google Scholar] [CrossRef] [PubMed]
- Spagnolo, P.; Sato, H.; Grutters, J.C.; Renzoni, E.A.; Marshall, S.E.; Ruven, H.J.; Wells, A.U.; Tzouvelekis, A.; van Moorsel, C.H.; van den Bosch, J.M.; et al. Analysis of BTNL2 genetic polymorphisms in British and Dutch patients with sarcoidosis. Tissue Antigens 2007, 70, 219–227. [Google Scholar] [CrossRef]
- Narula, N.; Iannuzzi, M. Sarcoidosis: Pitfalls and Challenging Mimickers. Front. Med. (Lausanne) 2021, 7, 594275. [Google Scholar] [CrossRef]
- Rybicki, B.A.; Kirkey, K.L.; Major, M. Familial risk ratio of sarcoidosis in African-American sibs and parents. Am. J. Epidemiol. 2001, 153, 188–193. [Google Scholar] [CrossRef]
- McGrath, D.S.; Daniil, Z.; Foley, P. Epidemiology of familial sarcoidosis in the UK. Thorax 2000, 55, 751–754. [Google Scholar] [CrossRef]
- Grunewald, J.; Eklund, A. Löfgren’s syndrome: Human leukocyte antigen strongly influences the disease course. Am. J. Respir. Crit. Care Med. 2009, 179, 307–312. [Google Scholar] [CrossRef]
- Grunewald, J. HLA associations and Löfgren’s syndrome. Expert Rev. Clin. Immunol. 2012, 8, 55–62. [Google Scholar] [CrossRef]
- Sato, H.; Woodhead, F.A.; Ahmad, T.; Grutters, J.C.; Spagnolo, P.; van den Bosch, J.M.M.; Maier, L.A.; Newman, L.S.; Nagai, S.; Izumi, T.; et al. Sarcoidosis HLA class II genotyping distinguishes differences of clinical phenotype across ethnic groups. Hum. Mol. Genet. 2010, 19, 4100–4111. [Google Scholar] [CrossRef] [PubMed]
- Iannuzzi, M.C. Genetics of sarcoidosis. Semin. Respir. Crit. Care Med. 2007, 28, 15–21. [Google Scholar] [CrossRef] [PubMed]
- Mangalam, A.K.; Taneja, V.; David, C.S. HLA class II molecules influence susceptibility versus protection in inflammatory diseases by determining the cytokine profile. J. Immunol. 2013, 190, 513–518. [Google Scholar] [CrossRef] [PubMed]
- Wennerström, A.; Pietinalho, A.; Vauhkonen, H.; Lahtela, L.; Palikhe, A.; Hedman, J.; Purokivi, M.; Varkki, E.; Seppänen, M.; Lokki, M.L. Finnish Sarcoidosis Study Group. HLA-DRB1 allele frequencies and C4 copy number variation in Finnish sarcoidosis patients and associations with disease prognosis. Hum. Immunol. 2012, 73, 93–100. [Google Scholar] [CrossRef] [PubMed]
- Zhou, Y.; Shen, L.; Zhang, Y.; Jiang, D.; Li, H. Human leukocyte antigen-A, -B, and -DRB1 alleles and sarcoidosis in Chinese Han subjects. Hum. Immunol. 2011, 72, 571–575. [Google Scholar] [CrossRef]
- Darlington, P.; Tallstedt, L.; Padyukov, L.; Kockum, I.; Cederlund, K.; Eklund, A.; Grunewald, J. HLA-DRB1* alleles and symptoms associated with Heerfordt’s syndrome in sarcoidosis. Eur. Respir. J. 2011, 38, 1151–1157. [Google Scholar] [CrossRef]
- Grunewald, J.; Brynedal, B.; Darlington, P.; Nisell, M.; Cederlund, K.; Hillert, J.; Eklund, A. Different HLA-DRB1* allele distributions in distinct clinical subgroups of sarcoidosis patients. Respir. Res. 2010, 11, 25. [Google Scholar] [CrossRef]
- Rossman, M.D.; Thompson, B.; Frederick, M.; Maliarik, M.; Iannuzzi, M.C.; Rybicki, B.A.; Pandey, J.P.; Newman, L.S.; Magira, E.; Beznik-Cizman, B. ACCESS Group. HLA-DRB1*1101: A significant risk factor for sarcoidosis in blacks and whites. Am. J. Hum. Genet. 2003, 73, 720–735. [Google Scholar] [CrossRef]
- Kaya, Z.; Gönen, S.; Caliskan, B.; Kemer, Z.; Ünal, A.B.; Değirmenci, E. HLA genotypes in Turkish hematopoietic cell recipients and likelihood of finding a matched donor through family searches. Exp. Clin. Transpl. 2017, 17, 813–818. [Google Scholar] [CrossRef]
- Ozyilmaz, E.; Goruroglu Ozturk, O.; Yunsel, D.; Deniz, A.; Hanta, I.; Kuleci, S.; Seydaoglu, G.; Erken, E.; Kocabas, A. Could HLA-DR B1*11 allele be a clue for predicting extra-pulmonary sarcoidosis? Sarcoidosis Vasc. Diffus. Lung Dis. 2014, 31, 154–162. [Google Scholar]
- Levin, A.M.; Adrianto, I.; Datta, I.; Iannuzzi, M.C.; Trudeau, S.; Li, J.; Drake, W.P.; Montgomery, C.G.; Rybicki, B.A. Association of HLA-DRB1 with Sarcoidosis Susceptibility and Progression in African Americans. Am. J. Respir. Cell Mol. Biol. 2015, 53, 206–216. [Google Scholar] [CrossRef] [PubMed]
- Rybicki, B.A.; Iannuzzi, M.C. Sarcoidosis and human leukocyte antigen class I and II genes: It takes two to tango? Am. J. Respir. Crit. Care Med. 2004, 169, 665–666. [Google Scholar] [CrossRef]
- Tana, C.; Donatiello, I.; Caputo, A.; Tana, M.; Naccarelli, T.; Mantini, C.; Ricci, F.; Ticinesi, A.; Meschi, T.; Cipollone, F.; et al. Clinical Features, Histopathology and Differential Diagnosis of Sarcoidosis. Cells 2022, 11, 59. [Google Scholar] [CrossRef]
- Sève, P.; Pacheco, Y.; Durupt, F.; Jamilloux, Y.; Gerfaud-Valentin, M.; Isaac, S.; Boussel, L.; Calender, A.; Androdias, G.; Valeyre, D.; et al. Sarcoidosis: A Clinical Overview from Symptoms to Diagnosis. Cells 2021, 10, 766. [Google Scholar] [CrossRef] [PubMed]
- Shah, K.K.; Pritt, B.S.; Alexander, M.P. Histopathologic review of granulomatous inflammation. J. Clin. Tuberc. Other Mycobact. Dis. 2017, 7, 1–12. [Google Scholar] [CrossRef] [PubMed]
- Dave, N.; Chevour, P.; Mahendradas, P.; Venkatesh, A.; Kawali, A.; Shetty, R.; Ghosh, A.; Sethu, S. Increased Aqueous Humor CD4+/CD8+ Lymphocyte Ratio in Sarcoid Uveitis. Ocul. Immunol. Inflamm. 2019, 27, 1033–1040. [Google Scholar] [CrossRef] [PubMed]
- Gupta, N.; Rajwanshi, A.; Gupta, D. Schaumann body in a case of sarcoidosis diagnosed on transbronchial FNAC. J. Cytol. 2011, 28, 88–89. [Google Scholar] [CrossRef]
- Winters, R.; Kida, M.; Cooper, K. Hamazaki-Wesenberg bodies in two patients with no history of sarcoidosis. J. Clin. Pathol. 2007, 60, 1169–1171. [Google Scholar] [CrossRef]
- Doubková, M.; Hausnerová, J.; Výška, O.; Richter, S.; Merta, Z. Necrotising sarcoid granulomatosis. A rare granulomatous disease. Sarcoidosis Vasc. Diffuse Lung Dis. 2018, 35, 395–398. [Google Scholar]
- Judson, M.A. Granulomatous Sarcoidosis Mimics. Front. Med. 2021, 8, 680989. [Google Scholar] [CrossRef]
- Panselinas, E.; Judson, M.A. Acute pulmonary exacerbations of sarcoidosis. Chest 2012, 142, 827–836. [Google Scholar] [CrossRef] [PubMed]
- Gerke, A.K. Morbidity and mortality in sarcoidosis. Curr. Opin. Pulm. Med. 2014, 20, 472–478. [Google Scholar] [CrossRef] [PubMed]
- Sehgal, N.V.; Riyaz, N.; Chatterjee, K.; Venkatash, P.; Sharma, S. Sarcoidosis as a systemic disease. Clin. Dermatol. 2014, 32, 351–363. [Google Scholar] [CrossRef] [PubMed]
- Te, H.S.; Perlman, D.M.; Shenoy, C.; Steinberger, D.J.; Cogswell, R.J.; Roukoz, H.; Peterson, E.J.; Zhang, L.; Allen, T.L.; Bhargava, M. Clinical characteristics and organ system involvement in sarcoidosis: Comparison of the University of Minnesota Cohort with other cohorts. BMC Pulm. Med. 2020, 20, 155. [Google Scholar] [CrossRef] [PubMed]
- Walsh, S.L.F.; Wells, A.U.; Sverzellati, N.; Keir, G.J.; Calandriello, L.; Antoniou, K.M.; Copley, S.J.; Devaraj, A.; Maher, T.M.; Renzoni, E.; et al. An integrated clinicoradiological staging system for pulmonary sarcoidosis: A case-cohort study. Lancet Respir. Med. 2014, 2, 123–130. [Google Scholar] [CrossRef]
- Costabel, U. Sarcoidosis: Clinical update. Eur. Resp. J. 2001, 18, 56s–68s. [Google Scholar]
- Huang, C.T.; Heurich, A.E.; Sutton, A.L.; Lyons, H.A. Mortality in sarcoidosis. A changing pattern of the causes of death. Eur. J. Respir. Dis. 1981, 62, 231–238. [Google Scholar]
- Denny, M.C.; Fotino, A.D. The Heerfordt-Waldenström syndrome as an initial presentation of sarcoidosis. Proc. Bayl. Univ. Med. Cent. 2013, 26, 390–392. [Google Scholar] [CrossRef]
- Fraga, R.C.; Kakizaki, P.; Valente, N.Y.S.; Portocarrero, L.K.L.; Teixeira, M.F.S.; Senise, P.F. Do you know this syndrome? Heerfordt-Waldenström syndrome. Ann. Bras. Dermatol. 2017, 92, 571–572. [Google Scholar] [CrossRef]
- Bradley, D.; Baughman, R.P.; Raymond, L.; Kaufman, A.H. Ocular manifestations of Sarcoidosis. Semin. Respir. Crit. Care Med. 2002, 23, 543–548. [Google Scholar] [CrossRef]
- Vahdani, K.; Rose, G.E. Sarcoid-like granulomatous orbitopathy—Presentation, systemic involvement and clinical outcome. Eye 2021, 35, 470–476. [Google Scholar] [CrossRef] [PubMed]
- Prabhakaran, V.C.; Saeed, P.; Esmaeli, B.; Sullivan, T.J.; McNab, A.; Davis, G.; Valenzuela, A.; Leibovitch, I.; Kesler, A.; Sivak-Callcott, J.; et al. Orbital and adnexal sarcoidosis. Arch. Ophthalmol. 2007, 125, 1657–1662. [Google Scholar] [CrossRef] [PubMed]
- Marinò, M.; Ionni, I.; Lanzolla, G.; Sframeli, A.; Latrofa, F.; Rocchi, R.; Marcocci, C. Orbital diseases mimicking graves’ orbitopathy: A long-standing challenge in differential diagnosis. J. Endocrinol. Invest. 2020, 43, 401–411. [Google Scholar] [CrossRef] [PubMed]
- Kidd, D.P.; Burton, B.J.; Graham, E.M.; Plant, G.T. Optic neuropathy associated with systemic sarcoidosis. Neurol. Neuroimmunol. Neuroinflamm. 2016, 3, e270. [Google Scholar] [CrossRef] [PubMed]
- Ganesh, S.K.; Kaduskar, A.V. Optic nerve head granuloma as a primary manifestation of ocular sarcoidosis—A tertiary uveitis clinic experience. Oman J. Ophthalmol. 2015, 8, 157–161. [Google Scholar] [CrossRef]
- Bradshaw, M.J.; Pawate, S.; Koth, L.L.; Cho, T.A.; Gelfand, J.M. Neurosarcoidosis Pathophysiology, Diagnosis, and Treatment. Neurol. Neuroimmunol. Neuroinflamm. 2021, 8, e1084. [Google Scholar] [CrossRef]
- Ginat, D.T.; Dhillon, G.; Almast, J. Magnetic resonance imaging of neurosarcoidosis. J. Clin. Imaging Sci. 2011, 1, 15. [Google Scholar]
- Shah, R.; Roberson, G.H.; Cure, J.K. Correlation of MR Imaging Findings and Clinical Manifestations in Neurosarcoidosis. Am. J. Neuroradiol. 2009, 30, 953–961. [Google Scholar] [CrossRef]
- Matsou, A.; Tsaousis, K.T. Management of chronic ocular sarcoidosis: Challenges and solutions. Clin. Ophthalmol. 2018, 12, 519–532. [Google Scholar] [CrossRef]
- Gerke, A.K. Treatment of Sarcoidosis: A Multidisciplinary Approach. Front. Immunol. 2020, 11, 545413. [Google Scholar] [CrossRef]
- Dursun, D.; Akova, Y.; Bilezikçi, B. Scleritis associated with sarcoidosis. Ocul. Immunol. Inflamm. 2004, 12, 143–148. [Google Scholar] [CrossRef] [PubMed]
- Kansal, V.; Dollin, M. Ocular involvement in sarcoidosis. Br. J. Ophthalmol. 2017, 189, e609. [Google Scholar] [CrossRef] [PubMed][Green Version]
- Yang, S.J.; Salek, S.; Rosenbaum, J.T. Ocular sarcoidosis: New diagnostic modalities and treatment. Curr. Opin. Pulm. Med. 2017, 23, 458–467. [Google Scholar] [CrossRef]
- Yang, E.; van-Ossewaarde, N.J.; Norel, J.; van-Dam, L.N.T.; de Boer, J.H.; Rothova, A. Long-term visual prognosis of peripheral multifocal chorioretinitis. Am. J. Ophthalmol. 2015, 159, 690–697. [Google Scholar]
- Lezrek, O.; El Kaddoumi, M.; Cherkaoui, O. Candle wax dripping lesions in sarcoidosis. JAMA Ophthalmol. 2017, 135, e171845. [Google Scholar] [CrossRef] [PubMed]
- Hiraoka, M. Severe visual impairment due to an optic neuropathy and central retinal vein occlusion in a sarcoidosis patient. J. Ophth. Inflamm. Infect. 2020, 10, 6. [Google Scholar] [CrossRef]
- Feng, C.; Chen, Q.; Liu, W.; Bi, Y.; Qian, J.; Wang, M.; Sun, X.; Tian, G. Neurosarcoidosis presenting as CRVO combined CRAO: A biopsy-proven case report of a Chinese patient. BMC Ophthalmol. 2020, 20, 348. [Google Scholar] [CrossRef]
- Bodaghi, B.; Touitou, V.; Fardeau, C.; Chapelon, C.; LeHoang, P. Ocular sarcoidosis. La Presse Médicale 2012, 41, e349–e354. [Google Scholar] [CrossRef]
- Hamanaka, T.; Takei, A.; Takemura, T.; Oritsu, M. Pathological study of cases with secondary open-angle glaucoma due to sarcoidosis. Am. J. Ophthalmol. 2002, 134, 17–26. [Google Scholar] [CrossRef]
- Ohara, K.; Okubo, A.; Sasaki, H.; Kamata, K. Intraocular manifestations of systemic sarcoidosis. Jpn. J. Ophthalmol. 1992, 36, 452–457. [Google Scholar]
- Raevis, J.J.; Antonova, N.; Agemy, S. Ocular Involvement in Sarcoidosis. J. Rheumatol. 2018, 45, 580. [Google Scholar] [CrossRef] [PubMed]
- Khurana, R.N.; Parikh, J.G.; Rao, N.A. Sarcoid choroiditis simulating birdshot chorioretinopathy. Retin. Cases Brief Rep. 2008, 2, 301–303. [Google Scholar] [CrossRef]
- Wakefield, D.; Zierhut, M. Controversy: Ocular sarcoidosis. Ocul. Immunol. Inflamm. 2010, 18, 5–9. [Google Scholar] [CrossRef] [PubMed]
- Edelsten, C.; Pearson, A.; Joynes, E.; Stanford, M.R.; Graham, E.M. The ocular and systemic prognosis of patients presenting with sarcoid uveitis. Eye 1999, 13, 748–753. [Google Scholar] [CrossRef] [PubMed]
- Acharya, N.R.; Browne, E.N.; Mochizuki, M.; The International Ocular Sarcoidosis Working Group. Distinguishing Features of Ocular Sarcoidosis in an International Cohort of Uveitis Patients. Ophthalmology 2018, 125, 119–126. [Google Scholar] [CrossRef]
- Yanardag, H.; Caner, M.; Papila, I.; Uygun, S.; Demirci, S.; Karayel, T. Diagnostic value of peripheral lymph node biopsy in sarcoidosis: A report of 67 cases. Can. Respir. J. 2007, 14, 209–211. [Google Scholar] [CrossRef]
- Liu, D.; Birnbaum, A.D. Update on sarcoidosis. Curr. Opin. Ophthalmol. 2015, 26, 512–516. [Google Scholar] [CrossRef]
- Kahkouee, S.; Samadi, K.; Alai, A.; Abedini, A.; Rezaiian, L. Serum ACE Level in Sarcoidosis Patients with Typical and Atypical HRCT Manifestation. Pol. J. Radiol. 2016, 81, 458–461. [Google Scholar] [CrossRef]
- Ungprasert, P.; Carmona, E.M.; Crowson, C.S.; Matteson, E.L. Diagnostic Utility of Angiotensin-Converting Enzyme in Sarcoidosis: A Population-Based Study. Lung 2016, 194, 91–95. [Google Scholar] [CrossRef]
- Jones, N.P.; Tsierkezou, L.; Patton, N. Lymphopenia as a predictor of sarcoidosis in patients with uveitis. Br. J. Ophthalmol. 2016, 100, 1393–1396. [Google Scholar] [CrossRef]
- Ramos-Casals, M.; Retamozo, S.; Sisó-Almirall, A.; Pérez-Alvarez, R.; Pallarés, L.; Brito-Zerón, P. Clinically-useful serum biomarkers for diagnosis and prognosis of sarcoidosis. Exp. Rev. Clin. Immunol. 2019, 15, 391–405. [Google Scholar] [CrossRef] [PubMed]
- Burke, R.R.; Rybicki, B.A.; Sudhaker Rao, D. Calcium and vitamin D in sarcoidosis: How to assess and manage. Sem. Resp. Crit. Care Med. 2010, 31, 474–484. [Google Scholar] [CrossRef] [PubMed]
- Vanmaris, R.M.; Rijkers, G.T. Biological role of the soluble interleukin-2 receptor in sarcoidosis. Sarcoidosis Vasc. Diffus. Lung Dis. 2017, 34, 122–129. [Google Scholar]
- Vagal, A.S.; Shipley, R.; Meyer, C.A. Radiological manifestations of sarcoidosis. Clin. Dermatol. 2007, 25, 312–325. [Google Scholar] [CrossRef]
- Ors, F.; Gumus, S.; Aydogan, M. HRCT findings of pulmonary sarcoidosis; Relation to pulmonary function tests. Multidiscip. Respir. Med. 2013, 8, 8. [Google Scholar] [CrossRef]
- Malinowska, E.; Doboszyńska, A.; Śliwińska, A.; Buscombe, J.R.; Kulesza, G.; Moczulska, B.; Ćwikła, J. The use of 67Ga scintigraphy in patients with sarcoidosis. Nuclear Med. Rev. 2018, 21, 59–65. [Google Scholar] [CrossRef]
- Rodrigues, T.; Rocha, E.; Barcelos, A. Ocular and parotid sarcoidosis-panda sign. Acta Reumatol. Port. 2014, 39, 345–346. [Google Scholar]
- Nishiyama, Y.; Yamamoto, Y.; Fukunaga, K.; Takinami, H.; Iwado, Y.; Satoh, K.; Ohkawa, M. Comparative evaluation of 18F-FDG PET and 67Ga scintigraphy in patients with sarcoidosis. J. Nucl. Med. 2006, 47, 1571–1576. [Google Scholar]
- Keijsers, R.G.; Grutters, J.C.; Thomeer, M.; du Bois, R.M.; van Buul, M.M.; Lavalaye, J.; van den Bosch, J.M.; Verzijlbergen, F.J. Imaging the inflammatory activity of sarcoidosis: Sensitivity and inter observer agreement of (67)Ga imaging and (18)F-FDG PET. Q. J. Nucl. Med. Mol. Imaging 2011, 55, 66–71. [Google Scholar]
- Israel, O.; Pellet, O.; Biassoni, L.; de Palma, D.; Estrada-Lobato, E.; Gnanasegaran, G.; Kuwert, T.; La Fougère, C.; Mariani, G.; Massalha, S.; et al. Two decades of SPECT/CT—The coming of age of a technology: An updated review of literature evidence. Eur. J. Nucl. Med. Mol. Imaging 2019, 46, 1990–2012. [Google Scholar] [CrossRef]
- Sobic-Saranovic, D.; Grozdic, I.; Videnovic-Ivanov, J.; Vucinic-Mihailovic, V.; Artiko, V.; Saranovic, D.; Djuric-Stefanovic, A.; Masulovic, D.; Odalovic, S.; Ilic-Dudvarski, A.; et al. The Utility of 18F-FDG PET/CT for Diagnosis and Adjustment of Therapy in Patients with Active Chronic Sarcoidosis. J. Nucl. Med. 2012, 53, 1543–1549. [Google Scholar] [CrossRef] [PubMed]
- Chen, H.; Jin, R.; Wang, Y.; Li, L.; Li, K.; He, Y. The Utility of 18F-FDG PET/CT for Monitoring Response and Predicting Prognosis after Glucocorticoids Therapy for Sarcoidosis. BioMed Res. Int. 2018, 2018, 1823710. [Google Scholar] [CrossRef] [PubMed]
- Welker, L.; Jorres, R.A.; Costabel, U.; Magnussen, H. Predictive value of BAL cell differentials in the diagnosis of interstitial lung diseases. Eur. Respir. J. 2004, 24, 1000–1006. [Google Scholar] [CrossRef]
- Kantrow, S.P.; Meyer, K.C.; Kidd, P.; Raghu, G. The CD4/CD8 ratio in BAL fluid is highly variable in sarcoidosis. Eur. Respir. J. 1997, 10, 2716–2721. [Google Scholar] [CrossRef]
- Danila, E.; Jurgauskiene, L.; Norkuniene, J.; Malickaite, R. BAL fluid cells in newly diagnosed pulmonary sarcoidosis with different clinical activity. Upsala J. Med. Sci. 2009, 114, 26–31. [Google Scholar] [CrossRef] [PubMed][Green Version]
- Shen, Y.; Pang, C.; Wu, Y.; Li, D.; Wan, C.; Liao, Z.; Yang, T.; Chen, L.; Wen, F. Diagnostic Performance of Bronchoalveolar Lavage Fluid CD4/CD8 Ratio for Sarcoidosis: A Meta-analysis. EBioMedicine 2016, 8, 302–308. [Google Scholar] [CrossRef] [PubMed]
- Mahendradas, P.; Maruyama, K.; Mizuuchi, K.; Kawali, A.; Kitaichi, N. Multimodal Imaging in Ocular Sarcoidosis. Ocul. Immunol. Inflamm. 2020, 28, 1205–1211. [Google Scholar] [CrossRef]
- Durrani, K.; Foster, C.S. Fundus autofluorescence imaging in posterior uveitis. Semin. Ophthalmol. 2012, 27, 228–235. [Google Scholar] [CrossRef]
- Tugal-Tutkun, I.; Herbort, C.P., Jr.; Mantovani, A.; Neri, P.; Khairallah, M. Advances and potential new developments in imaging techniques for posterior uveitis. Part 1: Noninvasive imaging methods. Eye 2021, 35, 33–51. [Google Scholar] [CrossRef]
- Samy, A.; Lightman, S.; Ismetova, F.; Talat, L.; Tomkins-Netzer, O. Role of Autofluorescence in Inflammatory/Infective Diseases of the Retina and Choroid. J. Ophthalmol. 2014, 2014, 418193. [Google Scholar] [CrossRef]
- Marchese, A.; Agarwal, A.; Moretti, A.G.; Handa, S.; Modorati, G.; Querques, G.; Bandello, F.; Gupta, V.; Miserocchi, E. Advances in imaging of uveitis. Ther. Adv. Ophthalmol. 2020, 12, 2515841420917781. [Google Scholar] [CrossRef] [PubMed]
- El Ameen, A.; Herbort, C.P., Jr. Comparison of Retinal and Choroidal Involvement in Sarcoidosis-related Chorioretinitis Using Fluorescein and Indocyanine Green Angiography. J. Ophthalmic Vis. Res. 2018, 13, 426–432. [Google Scholar] [CrossRef] [PubMed]
- Matsuo, T.; Itami, M.; Shiraga, F. Choroidopathy in patients with sarcoidosis observed by simultaneous indocyanine green and fluorescein angiography. Retina 2000, 20, 16–21. [Google Scholar] [CrossRef] [PubMed]
- Herbort, C.P., Jr.; Neri, P.; Papasavvas, I. Clinicopathology of non-infectious choroiditis: Evolution of its appraisal during the last 2-3 decades from “white dot syndromes” to precise classification. J. Ophthalmic Inflamm. Infect. 2021, 11, 43. [Google Scholar] [CrossRef]
- Herbort, C.P., Jr. Fluorescein and indocyanine green angiography for uveitis. Middle East Afr. J. Ophthalmol. 2009, 16, 168–187. [Google Scholar]
- Modi, Y.S.; Epstein, A.; Bhaleeya, S.; Harbour, J.W.; Albini, T. Multimodal imaging of sarcoid choroidal granulomas. J. Ophthalmic Inflamm. Infect. 2013, 3, 58. [Google Scholar] [CrossRef]
- Leder, H.A.; Campbell, J.P.; Sepah, Y.J.; Gan, T.; Dunn, J.P.; Hatef, E.; Cho, B.; Ibrahim, M.; Bittencourt, M.; Channa, R.; et al. Ultra-wide-field retinal imaging in the management of non-infectious retinal vasculitis. J. Ophthalmic Inflamm. Infect. 2013, 3, 30. [Google Scholar] [CrossRef]
- Campbell, J.P.; Leder, H.A.; Sepah, Y.J.; Channa, R.; Do, D.V.; Nguyen, Q.D. Wide-field retinal imaging in the management of noninfectious posterior uveitis. Am. J. Ophthalmol. 2012, 154, 908–911. [Google Scholar] [CrossRef]
- Parrulli, S.; Invernizzi, A.; Monteduro, D.; Zicarelli, F.; Oldani, M.; Staurenghi, G.; Woodstock, E.; Hay, S.; Neri, P.; Pichi, F. Longitudinal follow-up of choroidal granulomas with indocyanine green angiography and optical coherence tomography angiography: A Lesion-Based Analysis. Retina 2022, 42, 906–914. [Google Scholar] [CrossRef]
- Herbort, C.P.; LeHoang, P.; Guex-Crosier, Y. Schematic interpretation of indocyanine green angiography in posterior uveitis using a standard angiographic protocol. Ophthalmology 1998, 105, 432–440. [Google Scholar] [CrossRef]
- Wolfensberger, T.J.; Herbort, C.P. Indocyanine green angiographic features in ocular sarcoidosis. Ophthalmology 1999, 106, 285–289. [Google Scholar] [CrossRef]
- Goldberg, N.R.; Jabs, D.A.; Busingye, J. Optical coherence tomography imaging of presumed sarcoid retinal and optic nerve nodules. Ocul. Immunol. Inflamm. 2016, 24, 293–296. [Google Scholar] [CrossRef] [PubMed]
- Invernizzi, A.; Agarwal, A.; Mapelli, C.; Ngyen, Q.D.; Staurenghi, G.; Viola, F. Longitudinal follow-up of choroidal granulomas using enhanced depth imaging optical coherence tomography. Retina 2017, 37, 144–153. [Google Scholar] [CrossRef] [PubMed]
- Pichi, F.; Sarraf, D.; Morara, M.; Mazumdar, S.; Neri, P.; Gupta, V. Pearls and pitfalls of optical coherence tomography angiography in the multimodal evaluation of uveitis. J. Ophthalmic Inflamm. Infect. 2017, 7, 20. [Google Scholar] [CrossRef]
- Mahendradas, P.; Madhu, S.; Kawali, A.; Govindaraj, I.; Gowda, P.B.; Vinekar, A.; Shetty, N.; Shetty, R.; Shetty, B.K. Combined depth imaging of choroid in uveitis. J. Ophthalmic Inflamm. Infect. 2014, 4, 18. [Google Scholar] [CrossRef][Green Version]
- Baltmr, A.; Lightman, S.; Tomkins-Netzer, O. Examining the Choroid in Ocular Inflammation: A Focus on Enhanced Depth Imaging. J. Ophthalmol. 2014, 2014, 459136. [Google Scholar] [CrossRef] [PubMed]
- Invernizzi, A.; Mapelli, C.; Viola, F.; Cigada, M.; Cimino, L.; Ratiglia, R.; Staurenghi, G.; Gupta, A. Choroidal granulomas visualized by enhanced depth imaging optical coherence tomography. Retina 2015, 35, 525–531. [Google Scholar] [CrossRef]
- Hirukawa, K.; Keino, H.; Watanabe, T.; Okada, A.A. Enhanced depth imaging optical coherence tomography of the choroid in new-onset acute posterior scleritis. Graefes Arch. Clin. Exp. Ophthalmol. 2013, 251, 2273–2275. [Google Scholar] [CrossRef]
- Güngör, S.G.; Akkoyun, I.; Reyhan, N.H.; Yeşilırmak, N.; Yılmaz, G. Choroidal thickness in ocular sarcoidosis during quiescent phase using enhanced depth imaging optical coherence tomography. Ocul. Immunol. Inflamm. 2014, 22, 287–293. [Google Scholar] [CrossRef]
- Agarwal, A.; Mahajan, S.; Khairallah, M.; Mahendradas, P.; Gupta, A.; Gupta, V. Multimodal Imaging in Ocular Tuberculosis. Ocul. Immunol. Inflamm. 2017, 25, 134–145. [Google Scholar] [CrossRef]
- Berkowitz, S.T.; Brock, A.L.; Reichstein, D.A. An amelanotic choroidal melanoma arising in a young man with tattoo-associated sarcoidosis. Am. J. Ophthalmol. Case Rep. 2020, 18, 100655. [Google Scholar] [CrossRef] [PubMed]
- Papavasileiou, E.; Miller, J.B.; Sobrin, L. Swept-source optical coherence tomography findings in convalescent phase of treated sarcoid choroidal granulomas. Retin Cases Brief Rep. 2016, 10, 32–36. [Google Scholar] [CrossRef] [PubMed]
- Karti, O.; Saatci, A.O. Optical Coherence Tomography Angiography in Eyes with Non-infectious Posterior Uveitis; Some Practical Aspects. Med. Hypothesis Discov. Innov. Ophthalmol. 2019, 8, 312–322. [Google Scholar]
- Dingerkus, V.L.S.; Munk, M.R.; Brinkmann, M.P.; Freiberg, F.J.; Heussen, F.M.A.; Kinzl, S.; Lortz, S.; Orgül, S.; Becker, M. Optical coherence tomography angiography (OCTA) as a new diagnostic tool in uveitis. J. Ophthalmic Inflamm. Infect. 2019, 9, 10. [Google Scholar] [CrossRef] [PubMed]
- Cerquaglia, A.; Iaccheri, B.; Fiore, T.; Fruttini, D.; Belli, F.B.; Khairallah, M.; Lupidi, M.; Cagini, C. New Insights on Ocular Sarcoidosis: An Optical Coherence Tomography Angiography Study. Ocul. Immunol. Inflamm. 2019, 27, 1057–1066. [Google Scholar] [CrossRef] [PubMed]
- Fardeau, C.; Champion, E.; Massamba, N.; LeHoang, P. Uveitic macular edema. Eye 2016, 30, 1277–1292. [Google Scholar] [CrossRef] [PubMed]
- Massa, H.; Pipis, S.Y.; Adewoyin, T.; Vergados, A.; Patra, S.; Panos, G.D. Macular edema associated with non-infectious uveitis: Pathophysiology, etiology, prevalence, impact and management challenges. Clin. Ophthalmol. 2019, 13, 1761–1777. [Google Scholar] [CrossRef] [PubMed]
- Williams, D.M. Clinical Pharmacology of Corticosteroids. Resp. Care 2018, 63, 655–670. [Google Scholar] [CrossRef]
- Nunes Mayer, G.; Longo, M.; Brandi Gomes, B.; Junqueira Nobrega, M. Low dose corticosteroid in association with methotrexate for therapy of ocular sarcoidosis: Report of a case. Int. J. Retin. Vitr. 2015, 1, 7. [Google Scholar] [CrossRef]
- Imrie, F.R.; Dick, A.D. Biologics in the treatment of uveitis. Curr. Opin. Ophtalmol. 2007, 18, 481–486. [Google Scholar] [CrossRef]
- Durrani, K.; Kempen, J.H.; Ying, G.S.; Kacmaz, R.O.; Artornsombudh, P.; Rosenbaum, J.T.; Suhler, E.B.; Thorne, J.E.; Jabs, D.A.; Levy-Clarke, G.A.; et al. Systemic Immunosuppressive Therapy for Eye Diseases Site Research Group. Adalimumab for Ocular Inflammation. Ocul. Immunol. Inflamm. 2017, 25, 405–412. [Google Scholar] [CrossRef] [PubMed]
- Beccastrini, E.; Vannozzi, L.; Bacherini, D.; Squatrito, D.; Emmi, L. Successful Treatment of Ocular Sarcoidosis with Rituximab. Ocul. Immunol. Inflamm. 2013, 21, 244–246. [Google Scholar] [CrossRef] [PubMed]
- Bargagli, E.; Olivieri, C.; Rottoli, P. Cytokine modulators in the treatment of sarcoidosis. Rheumatol. Int. 2011, 31, 1539–1544. [Google Scholar] [CrossRef] [PubMed]
- Marquet, A.; Chapelon-Abric, C.; Maucort-Boulch, D.; Cohen-Aubart, F.; Pérard, L.; Bouillet, L.; Abad, S.; Bielefeld, P.; Bouvry, D.; André, M.; et al. Groupe Sarcoïdose Francophone. Efficacy and safety of TNF antagonists in ocular sarcoidosis: Data from the French registry STAT. Sarcoidosis Vasc. Diffuse Lung Dis. 2017, 34, 74–80. [Google Scholar] [PubMed]
- Thery-Casari, C.; Jamilloux, Y.; Bouvry, D.; Chapelon-Abric, C.; Marquet, A.; Bielefeld, P.; Schleinitz, N.; Vukusic, S.; Girszyn, N.; Fain, O.; et al. Outcome of patients with sarcoidosis refractory to TNF antagonists: A case series. Sarcoidosis Vasc. Diffuse Lung Dis. 2018, 35, 371–375. [Google Scholar]
- Deuter, C.M.E.; Kötter, I.; Günaydin, I.; Stübiger, N.; Doycheva, D.G.; Zierhut, M. Efficacy and tolerability of interferon alpha treatment in patients with chronic cystoid macular edema due to non-infectious uveitis. Br. J. Ophthalmol. 2009, 93, 906–913. [Google Scholar] [CrossRef]
- Plskova, J.; Greiner, K.; Forrester, J.V. Interferon-alpha as an effective treatment for noninfectious posterior uveitis and panuveitis. Am. J. Ophthalmol. 2007, 144, 55–61. [Google Scholar] [CrossRef]
- Bodaghi, B.; Gendron, G.; Wechsler, B. Efficacy of interferon alpha in the treatment of refractory and sight threatening uveitis: A retrospective monocentric study of 45 patients. Br. J. Ophthalmol. 2007, 91, 335–339. [Google Scholar] [CrossRef]
- Takase, H.; Acharya, N.R.; Babu, K.; Bodaghi, B.; Khairallah, M.; Mc Cluskey, P.J.; Tesavibul, N.; Thorne, J.E.; Tugal-Tutkun, I.; Yamamoto, J.H.; et al. Recommendations for the management of ocular sarcoidosis from the International Workshop on Ocular Sarcoidosis. Br. J. Ophthalmol. 2021, 105, 1515–1519. [Google Scholar] [CrossRef]
- Akova, Y.A.; Foster, C.S. Cataract Surgery in Patients with Sarcoidosis-associated Uveitis. Ophthalmology 1994, 101, 473–479. [Google Scholar] [CrossRef]
- Meskin, S.W.; Latkany, P.; Samson, C. Cataract Surgery Outcomes in Patients with Sarcoid Uveitis. Investig. Ophthalmol. Vis. Sci. 2003, 44, 13. [Google Scholar]
- Miserocchi, E.; Modorati, G.; di Matteo, F.; Galli, L.; Rama, P.; Bandello, F. Visual Outcome in Ocular Sarcoidosis: Retrospective Evaluation of Risk Factors. Eur. J. Ophthalmol. 2011, 21, 802–810. [Google Scholar] [CrossRef] [PubMed]
- Muñoz-Negrete, F.J.; Moreno-Montañés, J.; Hernández-Martínez, P.; Rebolleda, G. Current Approach in the Diagnosis and Management of Uveitic Glaucoma. Biomed. Res. Int. 2015, 2015, 742792. [Google Scholar] [CrossRef]
- Iwao, K.; Inatani, M.; Seto, T.; Takihara, Y.; Ogata-Iwao, M.; Okinami, S.; Tanihara, H. Long-term outcomes and prognostic factors for trabeculectomy with mitomycin c in eyes with uveitic glaucoma: A retrospective cohort study. J. Glaucoma 2014, 23, 88–94. [Google Scholar] [CrossRef] [PubMed]
- Vuori, M.-L. Molteno aqueous shunt as a primary surgical intervention for uveitic glaucoma: Long-term results. Acta Ophthalmol. 2010, 88, 33–36. [Google Scholar] [CrossRef] [PubMed]
- Papadaki, T.G.; Zacharopoulos, I.P.; Pasquale, L.R.; Christen, W.B.; Netland, P.A.; Foster, C.S. Long-term results of Ahmed glaucoma valve implantation for uveitic glaucoma. Am. J. Ophthalmol. 2007, 144, 62–69. [Google Scholar] [CrossRef] [PubMed]
- Sng, C.C.A.; Barton, K. Mechanism and management of angle closure in uveitis. Curr. Op. Ophthalmol. 2015, 26, 121–127. [Google Scholar] [CrossRef]
- Al Obeidan, S.A.; Osman, E.A.; Mousa, A.; Al-Muammar, A.M.; Abu El-Asrar, A.M. Long-term evaluation of efficacy and safety of deep sclerectomy in uveitic glaucoma. Ocul. Immunol. Inflamm. 2015, 23, 82–89. [Google Scholar] [CrossRef]
- Neri, P.; Lettieri, M.; Fortuna, C.; Manoni, M.; Giovannini, A. Inflammatory choroidal neovascularization. Middle East Afr. J. Ophthalmol. 2009, 16, 245–251. [Google Scholar]
- Agarwal, A.; Invernizzi, A.; Singh, R.B.; Foulsham, W.; Aggarwal, K.; Handa, S.; Agrawal, R.; Pavesio, C.; Gupta, V. An update on inflammatory choroidal neovascularization: Epidemiology, multimodal imaging, and management. J. Ophthalmic Inflamm. Infect. 2018, 8, 13. [Google Scholar] [CrossRef]
- Kim, M.; Lee, J.; Park, Y.-G.; Park, Y.-H. Long-term analysis of clinical features and treatment outcomes of inflammatory choroidal neovascularization. Am. J. Ophthalmol. 2022, 233, 18–29. [Google Scholar] [CrossRef] [PubMed]
- Cunningham, E.T., Jr.; Pichi, F.; Dolz-Marco, R.; Bailey Freund, K.; Zierhut, M. Inflammatory Choroidal Neovascularization. Ocul. Immunol. Inflamm. 2020, 28, 2–6. [Google Scholar] [CrossRef] [PubMed]
- Invernizzi, A.; Pichi, F.; Symes, R.; Zagora, S.; Agarwal, A.K.; Nguyen, P.; Erba, S.; Xhepa, A.; de Simone, L.; Cimino, L.; et al. Twenty-four-month outcomes of inflammatory choroidal neovascularisation treated with intravitreal anti-vascular endothelial growth factors: A comparison between two treatment regimens. Br. J. Ophthalmol. 2020, 104, 1052–1056. [Google Scholar] [CrossRef]
- Querques, L.; Querques, G.; Miserocchi, E. Intravitreal aflibercept for choroidal neovascularization in ocular sarcoidosis. Eur. J. Ophthalmol. 2016, 26, e124–e127. [Google Scholar] [CrossRef] [PubMed]
- Becker, M.; Davis, J. Vitrectomy in the Treatment of Uveitis. Am. J. Ophthalmol. 2005, 140, 1096–1105. [Google Scholar] [CrossRef]
- Bansal, R.; Dogra, M.; Chawla, R.; Kumar, A. Pars plana vitrectomy in uveitis in the era of microincision vitreous surgery. Ind. J. Ophthalmol. 2020, 68, 1844–1851. [Google Scholar] [CrossRef]
- Henry, C.R.; Becker, M.D.; Yang, Y.; Davis, J.L. Pars Plana Vitrectomy for the Treatment of Uveitis. Am. J. Ophthalmol. 2018, 190, 142–149. [Google Scholar] [CrossRef]
- Rybicki, B.A.; Maliarik, M.J.; Poisson, L.M.; Iannuzzi, M.C. Sarcoidosis and granuloma genes: A family-based study in African-Americans. Eur. Respir. J. 2004, 24, 251–257. [Google Scholar] [CrossRef]
- Beghè, D.; Dall’Asta, L.; Garavelli, C.; Pastorelli, A.A.; Muscarella, M.; Saccani, G.; Aiello, M.; Crisafulli, E.; Corradi, M.; Stacchini, P.; et al. Sarcoidosis in an Italian province. Prevalence and environmental risk factors. PLoS ONE 2017, 12, e0176859. [Google Scholar] [CrossRef]
- Lenner, R.; Schilero, G.J.; Padilla, M.L.; Teirstein, A.S. Sarcoidosis presenting in patients older than 50 years. Sarcoidosis Vasc. Diffus. Lung Dis. 2002, 19, 143–147. [Google Scholar]
- Jamilloux, Y.; Bonnefoy, M.; Valeyre, D.; Varron, L.; Broussolle, C.; Sève, P.; Jamilloux, Y. Elderly-onset sarcoidosis: Prevalence, clinical course and treatment. Drugs Aging 2013, 30, 969–978. [Google Scholar] [CrossRef] [PubMed]
- Judson, M.A.; Boan, A.D.; Lackland, D.T. The clinical course of sarcoidosis: Presentation, diagnosis, and treatment in a large white and black cohort in the United States. Sarcoidosis Vasc. Diffuse Lung Dis. 2012, 29, 119–127. [Google Scholar] [PubMed]
- Musellim, B.; Kumbasar, O.O.; Ongen, G.; Cetinkaya, E.; Turker, H.; Uzaslan, E.; Yenturk, E.; Uzun, O.; Saglam, L.; Celik, G.; et al. Epidemiological features of Turkish patients with sarcoidosis. Resp. Med. 2009, 103, 907–912. [Google Scholar] [CrossRef] [PubMed]
- Fernandez-Ramon, R.; Gaitan-Valdizan, J.J.; Sanchez-Bilbao, L.; Martin-Varillas, J.L.; Martinez-Lopez, D.; Demetrio-Pablo, R.; Gonzalez-Vela, M.C.; Cifrian, J.; Castaneda, S.; Llorca, J.; et al. Epidemiology of sarcoidosis in northern Spain, 1999–2019: A population-based study. Eur. J. Intern. Med. 2021, 91, 63–69. [Google Scholar] [CrossRef] [PubMed]
- Dana, M.R.; Merayo-Lloves, J.; Schaumberg, D.A.; Foster, C.S. Prognosticators for visual outcome in sarcoid uveitis. Ophthalmology 1996, 103, 1846–1853. [Google Scholar] [CrossRef]
- Kraaijvanger, R.; Janssen, B.N.; Vorselaars, A.D.M. Biomarkers in the Diagnosis and Prognosis of Sarcoidosis: Current Use and Future Prospects. Front. Immunol. 2020, 11, 1443. [Google Scholar] [CrossRef]
- Papasavvas, I.; Gehrig, B.; Herbort, C.P., Jr. The Comparative Value of Serum Angiotensin Converting Enzyme (ACE) and Lysozyme and the Use of Polyclonal Antibody Activation in the Work-up of Ocular Sarcoidosis. Diagnostics 2021, 11, 608. [Google Scholar] [CrossRef]
- Zur Bonsen, L.S.; Pohlmann, D.; Rübsam, A.; Pleyer, U. Findings and Graduation of Sarcoidosis-Related Uveitis: A Single-Center Study. Cells 2021, 11, 89. [Google Scholar] [CrossRef]
- Ishihara, M.; Meguro, A.; Ishido, M.; Takeuchi, M.; Shibuya, E.; Mizuki, N. Usefulness of Combined Measurement of Serum Soluble IL-2R and Angiotensin-Converting Enzyme in the Detection of Uveitis Associated with Japanese Sarcoidosis. Clin. Ophthalmol. 2020, 14, 2311–2317. [Google Scholar] [CrossRef]
- Gundlach, E.; Hoffmann, M.M.; Prasse, A.; Heinzelmann, S.; Ness, T. Interleukin-2 Receptor and Angiotensin-Converting Enzyme as Markers for Ocular Sarcoidosis. PLoS ONE 2016, 11, e0147258. [Google Scholar]
- Hadjadj, J.; Dechartres, A.; Chapron, T.; Assala, M.; Salah, S.; Dunogué, B.; Musset, L.; Baudin, B.; Groh, M.; Blanche, P.; et al. Relevance of diagnostic investigations in patients with uveitis: Retrospective cohort study on 300 patients. Autoimmun. Rev. 2017, 16, 504–511. [Google Scholar] [CrossRef] [PubMed]
- Kaiser, P.K.; Lowder, C.Y.; Sullivan, P.; Sanislo, S.R.; Kosmorsky, G.S. Chest computerized tomography in the evaluation of uveitis in elderly women. Am. J. Ophthalmol. 2002, 133, 499–505. [Google Scholar] [CrossRef]
- Clement, D.S.; Postma, G.; Rothova, A.; Grutters, J.C.; Prokop, M.; de Jong, P.A. Intraocular sarcoidosis: Association of clinical characteristics of uveitis with positive chest high-resolution computed tomography findings. Br. J. Ophthalmol. 2010, 94, 219–222. [Google Scholar] [CrossRef] [PubMed]
- Ganesh, S.K.; Roopleen, B.J.; Veena, N. Role of High-resolution Computerized Tomography (HRCT) of the chest in granulomatous uveitis: A tertiary uveitis clinic experience from India. Ocul. Immunol. Inflamm. 2011, 19, 51–57. [Google Scholar] [CrossRef]
- Mehta, S. Observed Patterns of Systemic Disease on PET/CT scan in patients with presumed ocular tuberculosis: Findings and hypotheses. Ocul. Immunol. Inflamm. 2018, 26, 217–219. [Google Scholar] [CrossRef]
- Sève, P.; Billotey, C.; Janier, M.; Grange, J.D.; Broussolle, C.; Kodjikian, L. Fluorodeoxyglucose positron emission tomography for the diagnosis of sarcoidosis in patients with unexplained chronic uveitis. Ocul. Immunol. Inflamm. 2009, 17, 179–184. [Google Scholar] [CrossRef]
- Rahmi, A.; Deshayes, E.; Maucort-Boulch, D.; Varron, L. Intraocular sarcoidosis: Association of clinical characteristics of uveitis with findings from 18F-labelled fluorodeoxyglucose positron emission tomography. Br. J. Ophthalmol. 2012, 96, 99–103. [Google Scholar] [CrossRef]
- Jamilloux, Y.; Kodjikian, L.; Broussolle, C.; Sève, P. Sarcoidosis and uveitis. Autoimmun. Rev. 2014, 13, 840–849. [Google Scholar] [CrossRef]
- Burger, C.; Holness, J.L.; Smit, D.P.; Griffith-Richards, S.; Koegelenberg, C.F.N.; Ellmann, A. The Role of 18F-FDG PET/CT in Suspected Intraocular Sarcoidosis and Tuberculosis. Ocul. Immunol. Inflamm. 2021, 29, 530–536. [Google Scholar] [CrossRef]
- Soriano, D.; Fähndrich, S.; Köhler, T.; Meschede, W.; Müller-Quernheim, J.; Zissel, G.; Frye, B.C. Normal values for bronchoalveolar lavage (BAL) differential cell count and lymphocyte subpopulations. Eur. Resp. J. 2021, 58, 684. [Google Scholar]
- Caspers, L.E.; Ebraert, H.; Makhoul, D.; Willermain, F.; Michel, O. Broncho-alveolar lavage (BAL) for the diagnosis of sarcoidosic uveitis. Ocul. Immunol. Inflamm. 2014, 22, 102–109. [Google Scholar] [CrossRef] [PubMed]
- Valeyre, D.; Jeny, F.; Rotenberg, C.; Bouvry, D.; Uzunhan, Y.; Sève, P.; Nunes, H.; Bernaudin, J.F. How to Tackle the Diagnosis and Treatment in the Diverse Scenarios of Extrapulmonary Sarcoidosis. Adv. Ther. 2021, 38, 4605–4627. [Google Scholar] [CrossRef]
- Hunter, D.G.; Foster, C.S. Ocular manifestations of sarcoidosis. In Principles and Practice of Ophthalmology; Albert, D.M., Jakobiec, F.A., Eds.; WB Saunders: Philadelphia, PA, USA, 1994; pp. 443–450. [Google Scholar]
- Belperio, J.A.; Shaikh, F.; Abtin, F.; Fishbein, M.C.; Saggar, R.; Tsui, E.; Lynch, J.P. Extrapulmonary sarcoidosis with a focus on cardiac, nervous system, and ocular involvement. eClinicalMedicine 2021, 37, 100966. [Google Scholar] [CrossRef] [PubMed]
- Radosavljević, A.; Jakšić, V.; Pezo, L.; Kovačević-Pavićević, D.; Ilić, A.; Mihailović-Vučinić, V. Clinical Features of Ocular Sarcoidosis in Patients with Biopsy-proven Pulmonary Sarcoidosis in Serbia. Ocul. Immunol. Inflamm. 2017, 25, 785–789. [Google Scholar] [CrossRef] [PubMed]
- Paovic, J.; Paovic, P.; Sredovic, V.; Jovanovic, S. Clinical manifestations, complications and treatment of ocular sarcoidosis: Correlation between visual efficiency and macular edema as seen on optical coherence tomography. Semin. Ophthalmol. 2016, 33, 202–209. [Google Scholar] [CrossRef] [PubMed]
- Perez-Alvarez, R.; Pérez-de-Lis, M.; Ramos-Casals, M.; BIOGEAS Study Group. Biologics-induced autoimmune diseases. Curr. Opin. Rheumatol. 2013, 25, 56–64. [Google Scholar] [CrossRef]

| Study | Year of Publicat. (Nation) | Sex (%) F | Mean Age (Year) | Prevalence of Ocul. Invol. (%) | Type of Uveitis (AU IU PU) (%) |
|---|---|---|---|---|---|
| Heiligenhaus A. [55] | 2011 (Germany) | 60.4 | 34.1 | 21.2 | AU 76.4 IU 17.3 PU 4.7 |
| Yanardagh A. [59] | 2018 (Turkey) | 55.8 | 46.2 | 46.5 | AU 35 PU 25 |
| Choi S.Y. [60] | 2018 (Korea) | 81.8 | 53.6 | 70.9 | AU 30.8 IU 25.6 PU 43.6 |
| Ungprasert P. [58] | 2019 (Usa) | 78 | 51.8 | 7–15 | AU 71 IU 21 PU 7 |
| Dammacco R. [57] | 2020 (Italy) | 64 | 53.3 | 28.7 | AU 36 IU 9.1 PU 21 |
| Medication | Mechanism of Action | Dose Administration | Onset of Action (Weeks) | Main Side Effects |
|---|---|---|---|---|
| Steroids | Blockage of inflammatory cascade (COX2 inhibition) | 0.5–1 mg/kg/day (oral–iv) | 1–4 days | Hypothalamic-pituitary-adrenal axis suppression Growth suppression Hirsutism Hyperglycemia Osteoporosis Immunosuppression Cataracts Glaucoma, Psychiatric disturbances |
| Azathioprine | Alteration of purine metabolism | 1–4 mg/kg/day (oral) | 4–12 |
|
| Methotrexate | Inibition of hydrofolate reductase | 7.5–25 mg/kg/week (oral–im) | 2–12 |
|
| Mycophenolate Mofetil | IMP-dehydrogenase inhibitor | 0.5–1.5 Mg twice daily (oral) | 2–12 |
|
| Cyclosporine A | T-cell inhibitor | 2.5–10 mg/kg/day twice daily (oral-Iv) | 2–6 |
|
| Tacrolimus | T-cell inhibitor | 0.15–0.30 mg/kg/day (oral-im) | 2–6 |
|
| Infliximab | Anti-TNFɑ | 5 mg/kg/day (iv) | 1–8 | Headache, nausea, skin rash, fever shortness of breath |
| Adalimumab | Anti-TNFɑ | 40 mg/2 weeks (sc) | 2–6 | Injection site reactions Increased risk of infections Skin rashes |
| Golimumab | Anti-TNFɑ | 50 mg/4 weeks (sc, iv) | 1–2 | Upper resp. tract infections Injection site reactions Joint pain Viral infections |
| Certolizumab | Anti-TNFɑ | 400 mg/4 weeks Maintenance (sc) | 6–12 | Same above |
| Tocilizumab | IL-6 receptor-antagonist | 4 mg/kg/4 weeks (iv) 162 mg/1–2weeks (sc) | 4 | Same above |
| Interferon ɑ 2a | Antiviral cytokine | 3–6 million IU (different regimens) (Im, iv, sc) | 24–48 h | Autoimmune diseases Anemia Flu-like syndrome Psychiatric symptoms |
| Rituximab | Anti-CD20 antigen | 500 mg or 1 g each 2 first weeks, then every 16–24 weeks (Iv, infusion) | 6–8 | Fever chills Anemia Muco-cutaneous reactions Infections Cold symptoms |
| Demographics | No. of pts | % |
|---|---|---|
| Patients | 235 | - |
| Eyes | 461 eyes | - |
| Ethnicity: Caucasian Others | 221 14 | 94 6 |
| Sex: Females Males | 158 77 | 67.2 32.8 |
| Definite OS Presumed OS | 172 63 | 73.2 26.8 |
| Bilaterality (eyes) | 393 eyes | 85.2 |
| No. of pts | % | |
|---|---|---|
| Previously diagnosed S | 35 | 14.9 |
| Systemic diagnosis at onset of OS | 120 | 51 |
| Late Diagnosis | 52 | 22.1 |
| No Systemic involvement | 28 | 11.9 |
| Biopsy Site | No. of pts | % | |
| Total | 172 | 73.2 | |
| Lungs | 94 | 54.6 | |
| Lymph nodes | 142 | 82.5 | |
| Skin | 59 | 34.3 | |
| Liver | 42 | 24.4 | |
| Lacrimal Gland | 27 | 15.7 | |
| BAL Findings | No. of pts | % | |
| Patients | 235 | 45.5 | |
| Positive | 72 | 67.3 | |
| Not specific | 35 | 32.7 | |
| Laboratory Exams | No. pts | Increased Levels | % |
| ACE | 235 | 66 | 28 |
| Lysozime | 83 | 33 | 39.7 |
| Calcemia | 235 | 121 | 51 |
| Calciuria | 235 | 127 | 5 |
| S-IL-2R | 43 | 36 | 82 |
| 18F-FDG-PET/CT | No. | % |
|---|---|---|
| Patients | 183 | 77.9 |
| Active disease | 99 | 42.1 |
| Thoracic localization | 34 | 14.5 |
| Extra-Toracic localization | 11 | 4.7 |
| Combination | 54 | 22.9 |
| Chest HRCT Findings | No. | % |
| Patients | 215 | 91.5 |
| Hilar and/or Mediastinic Lymphadenopathy | 142 | 60.4 |
| Parenchimal involvement | 94 | 40 |
| Combination | 31 | 13.2 |
| Negative | 16 | 6.8 |
| Treatment | No. pts/Eyes | % pts |
|---|---|---|
| Topical (CS+mydriatics) | 201/398 | 85.5 |
| Intravitreal implant | 62/94 | 24.3 |
| Anti-VEGF | 3/3 | 1.3 |
| Sistemic CS | 203 | 86.4 |
| CS+Azathioprine * | 12 | 5.1 |
| CS+Methotrexate * | 29 | 12.3 |
| CS+Mycophenolate M. * | 43 | 18.3 |
| CS+Adalimumab * | 11 | 4.7 |
| CS+Rituximab * | 3 | 1.3 |
| CS+Interferon α-2a * | 4 | 1.7 |
| Localization | No. pts | % |
|---|---|---|
| Orbit/Adnexa/Sclera/Conjunctiva | 21 | 8.9 |
| Anterior uveitis | 112 | 52.3 |
| Intermediate uveitis | 22 | 10.3 |
| Posterior uveitis | 62 | 28.9 |
| Panuveitis | 18 | 8.4 |
| Ocular Complications | % Eyes (461/100) | Eyes |
| Synechiae | 19.3 | 89 |
| Cataract | 91.3 | 421 |
| Glaucoma | 11.7 | 54 |
| CME | 31.9 | 147 |
| Epiretinal Membrane | 28.8 | 133 |
| CNV | 2.8 | 13 |
| Country | Sarcoidosis (%) |
|---|---|
| USA Rodriguez (1982–1992) | 9.6 |
| Switzerland Tran (1990–1993) | 5.9 |
| UK Jones (1991–2013) | 9.7 |
| France Bodaghi (1991–1996) Guillaud (2016) | 6.4 15.6 |
| Austria Barisani-Asenbauer (1995–2009) | 3.2 |
| Tunisia Khairallah (1992–2003) | 1.7 |
| Saudi Arabia Al Dhahri (1998–2013) | 4.4 |
| Germany Grajewski (2001–2006) Jacob (2012–2013) | 4.5 11.0 |
| Turkey Kazokogu (2004) | 0.9 |
| Spain Llorenc (2009–2012) | 3.0 |
| Japain Nakahara (2010–2012) | 9.4 |
| Italy Cimino (2013–2015) Cimino (2002–2008) Mercanti (1986–1993) Pivetti-Pezzi (1986–1993) | 4.3 2.2 0.8 0.2 |
Publisher’s Note: MDPI stays neutral with regard to jurisdictional claims in published maps and institutional affiliations. |
© 2022 by the authors. Licensee MDPI, Basel, Switzerland. This article is an open access article distributed under the terms and conditions of the Creative Commons Attribution (CC BY) license (https://creativecommons.org/licenses/by/4.0/).
Share and Cite
Allegri, P.; Olivari, S.; Rissotto, F.; Rissotto, R. Sarcoid Uveitis: An Intriguing Challenger. Medicina 2022, 58, 898. https://doi.org/10.3390/medicina58070898
Allegri P, Olivari S, Rissotto F, Rissotto R. Sarcoid Uveitis: An Intriguing Challenger. Medicina. 2022; 58(7):898. https://doi.org/10.3390/medicina58070898
Chicago/Turabian StyleAllegri, Pia, Sara Olivari, Federico Rissotto, and Roberta Rissotto. 2022. "Sarcoid Uveitis: An Intriguing Challenger" Medicina 58, no. 7: 898. https://doi.org/10.3390/medicina58070898
APA StyleAllegri, P., Olivari, S., Rissotto, F., & Rissotto, R. (2022). Sarcoid Uveitis: An Intriguing Challenger. Medicina, 58(7), 898. https://doi.org/10.3390/medicina58070898
